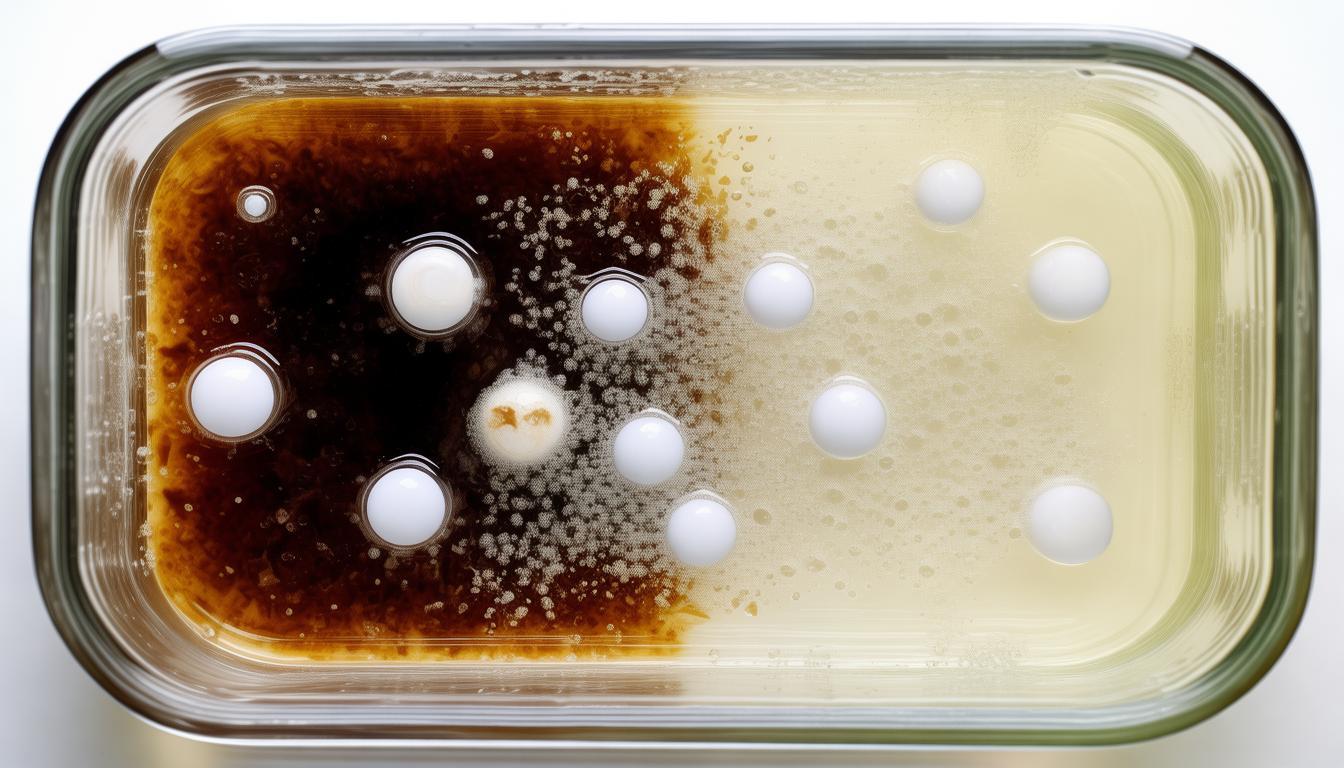
除油、除锈_除锈油怎么清洗_除锈除油剂配方

新闻资讯
NEWS
更新时间:2025-08-13
点击次数:95 清洁油污和去除铁锈在许多行业都十分关键,它关系到机器的正常运转、物品的优劣等。妥善处理油污和铁锈,可以增加物件的使用年限,也能改善它的外观和功能。现在我就来具体谈谈清洁油污和去除铁锈的细节。
油污来源
日常生活中,油渍的出处五花八门。在厨房,做饭时滴落的油会粘在锅碗瓢盆和墙壁上。工厂里,机器运转时用的机油、冷却液等会留在零件上。油渍如果清理不及时,会沾染灰尘,让机器运转不灵,也会让东西变脏。
铁锈成因
铁锈是金属跟空气里氧气和湿气作用生成的物质。户外铁质物件如栏杆、桥梁等,若长时间处在潮湿状态下,铁质会慢慢被氧化变成锈迹。锈迹会让金属变脆,表面出现色斑,对金属制品的使用安全性和耐久性造成很大影响。
除油方法
家里清洁油污通常使用洗洁精,这种清洁剂对于去除油脂很有作用。如果遇到难以清洗的油渍,可以尝试用热水稀释洗洁精,这样清洁能力会更强。工厂处理油污时,一般会采用有机溶剂,这类溶剂能迅速溶解油污,不过操作时必须保持空气流通,以防吸入有毒气体。
除锈方式
家里除锈可以用白醋,把生锈物件浸在里面,借助酸性能溶解氧化物。或者用砂纸擦掉锈迹,不过这样比较费劲。工厂里经常用化学药剂除锈,能迅速和锈层发生作用。又或者用喷砂方法除锈,靠高速砂子撞击来清除锈斑。
预防措施
要避免油渍形成,需要经常进行清理,以此降低油分的积聚。为了防止金属生锈,可以在物件表面刷上防锈涂料,以此阻挡空气和水分的接触。同时要维持环境干燥,防止金属长时间处在湿润的状态。
大家在做去油、去锈的工作时,碰见过哪些困难?如果觉得内容有帮助,记得要点击喜欢和转发。
公司邮箱: 735464328@qq.com
服务热线: 17730015921
公司地址: 陕西省西安市高陵区泾渭街办梁村工业园